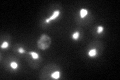
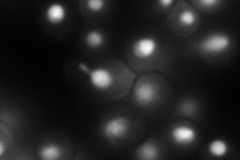
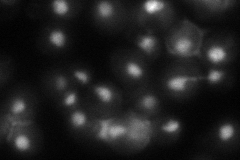
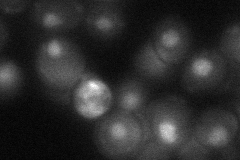
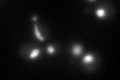

View description
Component of the Paf1p complex that binds to and modulates the activity of RNA polymerases I and II; required for expression of a subset of genes, including cyclin genes; contains TPR repeats
Localization:
Intensity:
Fold change:
Significance:
-
C’ GFP library in SD
nucleus58.18 -
N' NOP1pr-GFP in SD
nucleus,nucleolus107.933 -
N' TEF2pr-mCherry in SD

nucleus72.0404 -
N' NATIVEpr-GFP in SD
nucleus54.2956 -
N' TEF2pr-VC and Cyto-VN in SD
nucleus37.3883 -
C’ GFP library in SD+DTT
nucleus57.440.98No -
C’ GFP library in SD+H2O2

nucleus58.181No -
C’ GFP library in Starvation Media

nucleus42.150.72No -
C’ GFP library on the background of Pup2-DaMP

nucleus -
C’ GFP library on the background of CCT mutant

nucleus77.76991.33653No
